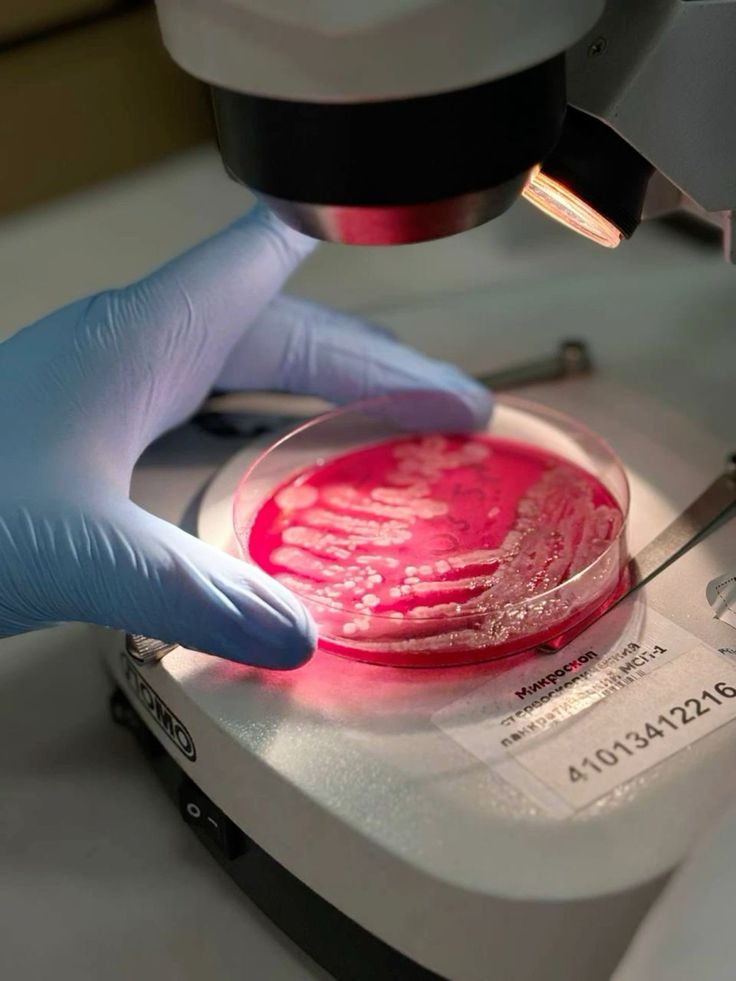
Microbes in Lab

What We Do
At SV Biotech, we believe the future of agriculture lies in working with soil biology, not overpowering it. Our microbial solutions are developed to improve nutrient efficiency, crop performance, and long-term soil health, helping farmers achieve consistent results while reducing dependence on excessive chemical inputs.
Founded on a strong base of microbiology and fermentation science, SV Biotech develops biological products that are reliable, practical, and scalable. Every SVGOLD® formulation is designed to perform in real field conditions, supporting regenerative agricultural practices without compromising productivity.
Backed by fermentation science and microbial research, our work extends from field-ready biofertilizers to scalable biological solutions, ensuring scientific integrity, responsible innovation, and farmer confidence—so productivity today does not come at the cost of soil health tomorrow.